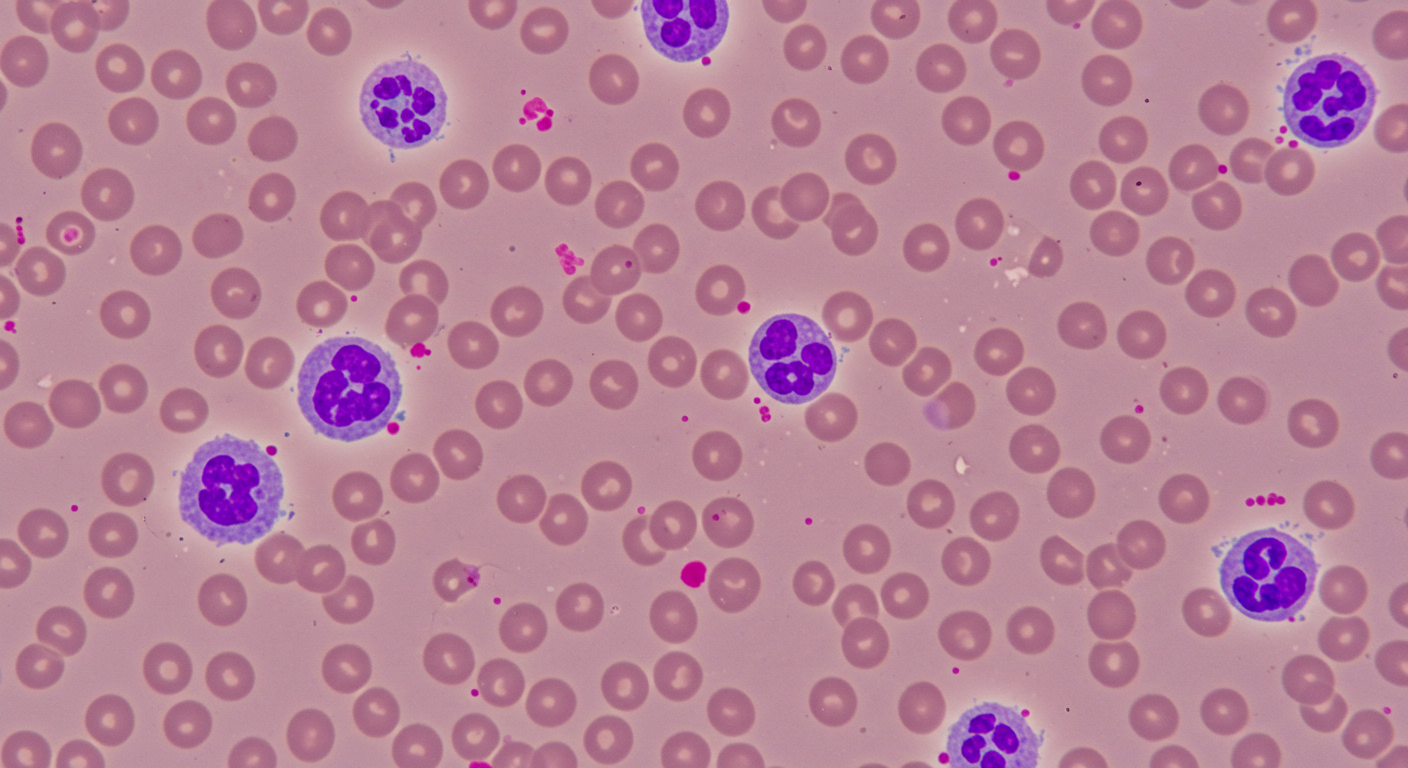
호중구 정상수치는 성인 기준 1&amp;#44;500~8&amp;#44;000/&mu;L.

건강검진 혈액검사에서 ‘호중구 수치’라는 항목을 보고 의아했던 적 있나요? 호중구는 백혈구 중 가장 큰 비중을 차지하며, 우리 몸의 면역을 지키는 최전선입니다.
수치가 낮으면 단순 피로가 아니라 면역력 저하의 심각한 신호일 수 있습니다. 오늘은 호중구 정상수치, 수치가 낮으면 어떤 의미인지, 올리는 방법까지 한 번에 정리해 드리겠습니다.

📌 목차
호중구 정상수치 – 왜 중요한 기준일까?



1. 호중구 정상수치의 기준
혈액검사에서 호중구는 보통 백분율(%)과 절대수치(ANC: Absolute Neutrophil Count) 두 가지 방식으로 표시됩니다.
- 백분율: 전체 백혈구 중 40%~70%가 정상 범위
- 절대수치(ANC): 성인의 경우 1,500~8,000/µL(마이크로리터당)
즉, 전체 백혈구의 절반 이상이 호중구일 만큼 중요한 비중을 차지하며, 이 수치가 너무 낮거나 높으면 면역 상태에 이상이 있다는 신호로 볼 수 있습니다.
2. 연령·상황에 따른 차이
- 성인: 1,500/µL 이상이면 정상 범위로, 500 이하로 떨어지면 심각한 면역저하(중증 호중구감소증)로 간주됩니다.
- 소아·신생아: 생리적으로 변동이 심해 정상 범위가 더 넓습니다. 신생아 시기에는 호중구가 높게 나올 수 있지만 점차 안정화됩니다.
- 노인: 면역력 저하와 함께 호중구 수치가 낮게 나올 수 있으므로, 단순 수치보다는 전반적인 건강 상태와 함께 해석해야 합니다.
3. 정상수치의 의미
호중구는 우리 몸의 ‘1차 면역군’으로 불립니다. 수치가 정상 범위 안에 있다는 것은, 세균·곰팡이 등 외부 병원체에 대해 즉각적인 방어 능력이 유지되고 있다는 뜻입니다.
- 정상 범위 유지: 감염에 대한 대응이 안정적으로 작동 중
- 정상보다 낮음: 감염에 쉽게 노출 → 세균성 폐렴, 요로감염, 구강 궤양 등
- 정상보다 높음: 급성 염증, 세균감염, 골수질환, 스트레스 반응 등 가능
4. 주의해야 할 점
호중구 수치는 단독으로만 해석하기보다는, 백혈구(WBC), 림프구, 혈소판, CRP(염증 지표) 등과 함께 종합적으로 확인해야 합니다. 예를 들어, 수치가 약간 낮아도 특별한 증상이 없다면 일시적일 수 있지만, 발열·잦은 감염이 동반되면 심각한 원인일 수 있습니다.
호중구 수치 낮으면 나타나는 증상과 위험성



1. 호중구 감소증이란?
호중구 수치가 1,500/µL 이하로 떨어진 상태를 ‘호중구 감소증’이라고 부릅니다. 이는 우리 몸의 면역력이 약해져, 평소라면 큰 문제가 되지 않는 작은 세균이나 곰팡이에도 쉽게 감염될 수 있다는 뜻입니다.
2. 호중구 수치가 낮을 때 나타나는 증상
호중구가 부족하면 감염에 대한 방어력이 약해져 작은 신호들도 위험 신호가 될 수 있습니다.
- 발열과 오한: 이유 없는 체온 상승, 땀, 오한이 반복
- 구강 문제: 구내염, 잇몸 통증, 구강 궤양
- 피부·상처 문제: 작은 상처도 곪고 잘 아물지 않음
- 호흡기·비뇨기 감염: 폐렴, 기관지염, 요로감염이 쉽게 발생
- 전신 증상: 피로감, 근육통, 체력 저하
3. 호중구 수치 단계별 위험성
아래 표는 호중구 수치가 낮아질 때의 단계별 증상과 위험도를 정리한 것입니다.
| 1,000~1,500 | 경미 감소 | 특별한 증상 없을 수도 있음, 피로감 | 비교적 낮음 | 정기검진, 생활관리 |
|---|---|---|---|---|
| 500~1,000 | 중등도 감소 | 발열, 구강염, 반복 감염 | 중간 | 원인 파악 후 치료 필요 |
| < 500 | 중증 감소 | 고열, 패혈증, 폐렴, 상처 회복 지연 | 매우 높음 | 응급 치료, 항생제, G-CSF 주사 |
👉 특히 500 이하로 떨어지면 응급상황으로 간주되며, 감염이 급격히 진행해 패혈증 같은 치명적인 상태로 악화될 수 있습니다.
4. 호중구 수치 낮아지는 주요 원인
- 항암치료 및 방사선치료 → 골수 기능이 억제되어 호중구 생성 자체가 줄어듦
- 바이러스 감염 → 간염, 독감, HIV 같은 질환은 일시적 감소를 유발
- 약물 부작용 → 일부 항생제, 갑상선 약, 항경련제 등
- 자가면역질환 → 루푸스(SLE) 같은 질환에서 면역세포가 스스로 호중구를 공격
- 영양결핍 → 비타민 B12, 엽산 부족
- 골수질환 → 재생불량성 빈혈, 백혈병 등
5. 호중구 감소 시 주의해야 할 응급 신호
호중구가 낮을 때 아래 증상이 동반되면 즉시 병원 내원해야 합니다.
- 갑작스러운 고열(38도 이상)
- 호흡 곤란, 기침, 흉통
- 혈뇨, 잦은 배뇨 시 통증
- 극심한 피로와 어지럼증
- 작은 상처에도 심한 염증 발생
호중구 수치 올리는 방법 – 생활습관부터 치료까지



1) 먼저 알아둘 것: ‘수치’보다 ‘상황’이 중요
- ANC(절대호중구수)가 1,500/µL 이상이면 대체로 정상, 1,000 미만이면 감염 위험이 커집니다.
- “낮게 나왔다”는 결과 하나만으로 단정하지 말고 증상(발열·오한·반복 감염), 복용 약, 최근 치료(항암·방사선), 영양 상태까지 함께 점검하세요.
- 38.0℃ 이상 발열 + ANC 500 미만은 응급 신호입니다. 즉시 진료가 필요합니다.
2) 생활 관리: 감염을 막고 골수 회복을 돕는 루틴
A. 식사·영양(‘뼈대’부터 든든히)
- 단백질: 살코기, 생선, 달걀, 두부·콩류를 매 끼니에 소량이라도 포함(호중구의 재생에 필수인 아미노산 공급).
- 비타민 B12·엽산: 소고기·간, 달걀, 유제품 / 시금치·브로콜리·아보카도(핵산 합성에 필요).
- 아연·구리: 굴·견과·콩류(면역세포 분화·기능에 관여).
- 비타민 C: 제철 과일·채소(항산화·상처회복 보조).
- 수분: 점액층·점막 방어력 유지를 위해 하루 1.5–2L 목표(신장·심부전 등 제한 지시가 있다면 의료진 권고 우선).
- 식중독·세균 노출 줄이기:
- 회·육회·덜 익힌 달걀, 비가열 유제품 피하기
- 날고기는 도마·칼 분리, 75℃ 이상 충분 조리
- 남은 음식은 2시간 내 냉장, 재가열 철저
영양제는 ‘도움이 될 수’는 있으나, 원인 교정 없이 수치를 올리는 해법은 아닙니다. 특히 철분·허브제 등은 복용 중인 약과 상호작용이 있을 수 있어 의료진과 상의 후 결정하세요.
B. 위생·환경(‘들어오는 길’부터 차단)
- 손 위생: 외출·화장실·식전·기침 후 비누 30초 또는 알코올 손소독.
- 마스크: 병원·대중교통·밀집 공간 방문 시 상시 착용.
- 생활공간: 자주 닿는 면(문손잡이·휴대폰) 정기 소독, 하루 2–3회 10분 이상 환기.
- 원예·애완동물 배설물 처리는 장갑·마스크 착용(흙·분변 통한 병원체 노출 감소).
C. 수면·스트레스·운동(‘회복 시스템’ 가동)
- 수면: 7–9시간, 일정한 취침·기상 시간으로 면역 리듬 안정.
- 스트레스 관리: 명상·호흡·짧은 산책. 코르티솔 과다는 면역세포 기능 저하 유발.
- 운동: 저·중강도 유산소 150분/주(걷기·자전거). 고강도·무리한 근력운동은 급성기엔 피하고, 발열·감염 증상 시 운동 중단.
D. 예방접종(의료진과 상의하여)
- 독감(인플루엔자) 비활성화 백신: 감염부담이 큰 계절에 권장.
- 폐렴구균 등: 기저질환·연령·면역상태에 따라 맞춤 권고.
- 생백신은 중등도 이상 면역저하 상태에선 제한될 수 있어 반드시 담당의와 상의.
3) 치료: ‘왜 낮아졌는지’를 바로잡는 게 핵심
A. 원인별 접근
- 약물성: 항갑상선제(메티마졸 등), 일부 항생제/항경련제/정신과 약물, 항염증제 등 → 유발약 중단·대체를 우선 검토.
- 감염성(바이러스 등): 일시 저하가 흔함 → 원인 치료 + 경과 관찰.
- 영양결핍: B12·엽산·구리 결핍 교정.
- 자가면역성: 필요 시 스테로이드/면역조절제 고려(전문의 판단).
- 골수성(재생불량·골수형성 이상·백혈병 등): 혈액내과 평가(골수검사 포함) 및 전문 치료.
B. 의학적 치료 옵션
- G-CSF(호중구 성장인자, 필그라스팀/페그필그라스팀): 항암 유발성 호중구감소증 등에서 가장 확실하게 수치를 올리는 표준 치료. 투여 주기·용량은 원인·위험도에 따라 결정.
- 예방적/경험적 항생제·항진균제: ANC<500 + 발열 또는 장기적 심한 저하에서 감염 사망률 감소를 위해 사용.
- IVIG(정맥 면역글로불린): 일부 자가면역성 중증에서 고려.
- 항암 용량·주기 조정: 화학요법 유발 시 감염 위험–치료 이득 균형을 보며 조정.
스테로이드·항생제의 임의 복용은 금물. 증상·수치·배양 결과를 바탕으로 의료진이 결정해야 내성·부작용을 줄일 수 있습니다.
4) 상황별 실전 가이드
① 경미한 저하(ANC 1,000–1,500) & 증상 없음
- 생활·영양 관리 강화, 2–4주 내 재검.
- 감염성 요인(코감기 등) 회복 후 자연 정상화되는 경우 많음.
② 중등도 저하(ANC 500–1,000) 또는 경미 저하 + 잦은 감염
- 원인 약물·질환 평가, 비타민 결핍 교정.
- 직장·학교·대중시설 방문 시 마스크 상시 + 손위생 철저.
- 담당의 판단 하에 G-CSF 간헐 투여 고려 가능.
③ 중증 저하(ANC <500) 또는 발열 동반
- 즉시 의료기관: 혈액배양·흉부영상·소변검사 등으로 감염원 탐지, 광범위 항생제 신속 투여.
- 필요 시 입원·격리·G-CSF 지속 투여.
5) 자주 하는 실수 & 체크리스트
피해야 할 것
- 날고기/반숙 달걀/비살균 유제품 섭취
- 사람 많이 모이는 장소에서 마스크 미착용
- 임의 항생제·스테로이드 복용, 민간요법만 의존
- 고열인데 “하루 지켜보자”로 지연
좋은 습관
- 식품 위생 수칙 준수(충분 가열·도마 분리)
- 손위생·표면 소독·주기적 환기
- 단백질·B12·엽산·아연 충분 섭취
- 수면 7–9시간, 스트레스 관리
- 발열 38.0℃ 이상이면 지체 없이 진료
Q&A: 호중구에 대해 자주 묻는 질문<
Q1. 호중구가 낮으면 꼭 위험한가요?
일시적으로 낮을 수 있지만, 장기간 낮으면 감염 위험이 커지므로 주의가 필요합니다.
Q2. 호중구가 높으면 어떤 의미인가요?
염증이나 세균 감염, 드물게는 혈액질환을 의미할 수 있습니다.
Q3. 호중구 수치를 음식으로 올릴 수 있나요?
단백질·비타민 B12·엽산·아연이 풍부한 음식을 먹으면 도움이 됩니다.
Q4. 호중구 감소가 있으면 생활에서 조심할 점은 무엇인가요?
손 위생 철저, 날 음식 피하기, 사람이 많은 장소 피하기가 중요합니다.
Q5. 호중구 수치가 낮으면 병원에서 어떻게 치료하나요?
원인 질환 치료, 필요 시 호중구 성장인자(G-CSF) 주사나 항생제 투여가 이뤄집니다.

마무리
호중구는 우리 몸의 면역 지표로, 수치가 정상 범위에서 벗어나면 반드시 원인 파악이 필요합니다. 특히 호중구 수치가 낮으면 사소한 감염도 큰 문제가 될 수 있으니 생활 관리와 함께 전문의 상담을 권장합니다. 꾸준한 건강 관리가 면역력을 지키는 첫걸음입니다.
'건강' 카테고리의 다른 글
| 고혈당 쇼크 증상과 원인 한눈에 정리 (지금 꼭 확인) (0) | 2025.09.02 |
|---|---|
| 크레아티닌 수치가 높으면? 정상치와 낮추는법 한눈에 정리 (0) | 2025.09.01 |
| 신부전증 증상과 원인 한눈에 보기 (지금 꼭 확인하세요) (0) | 2025.08.31 |
| 자궁 반응성 세포변화 원인·치료 총정리 (검사 결과 해석까지) (0) | 2025.08.30 |
| 여자 오른쪽 아랫배 통증 원인과 치료 한눈에 (질환 신호일 수도!) (0) | 2025.08.26 |
| 콜린성 두드러기 원인·증상·치료 완벽 가이드 (증상 확인 필수) (0) | 2025.08.25 |
| 오른쪽 옆구리 통증 원인부터 증상·치료까지 한눈에 (지금 알아두세요) (0) | 2025.08.24 |
| 뇌진탕 초기증상부터 후유증·치료까지 (지금 꼭 알아두세요) (0) | 2025.08.23 |